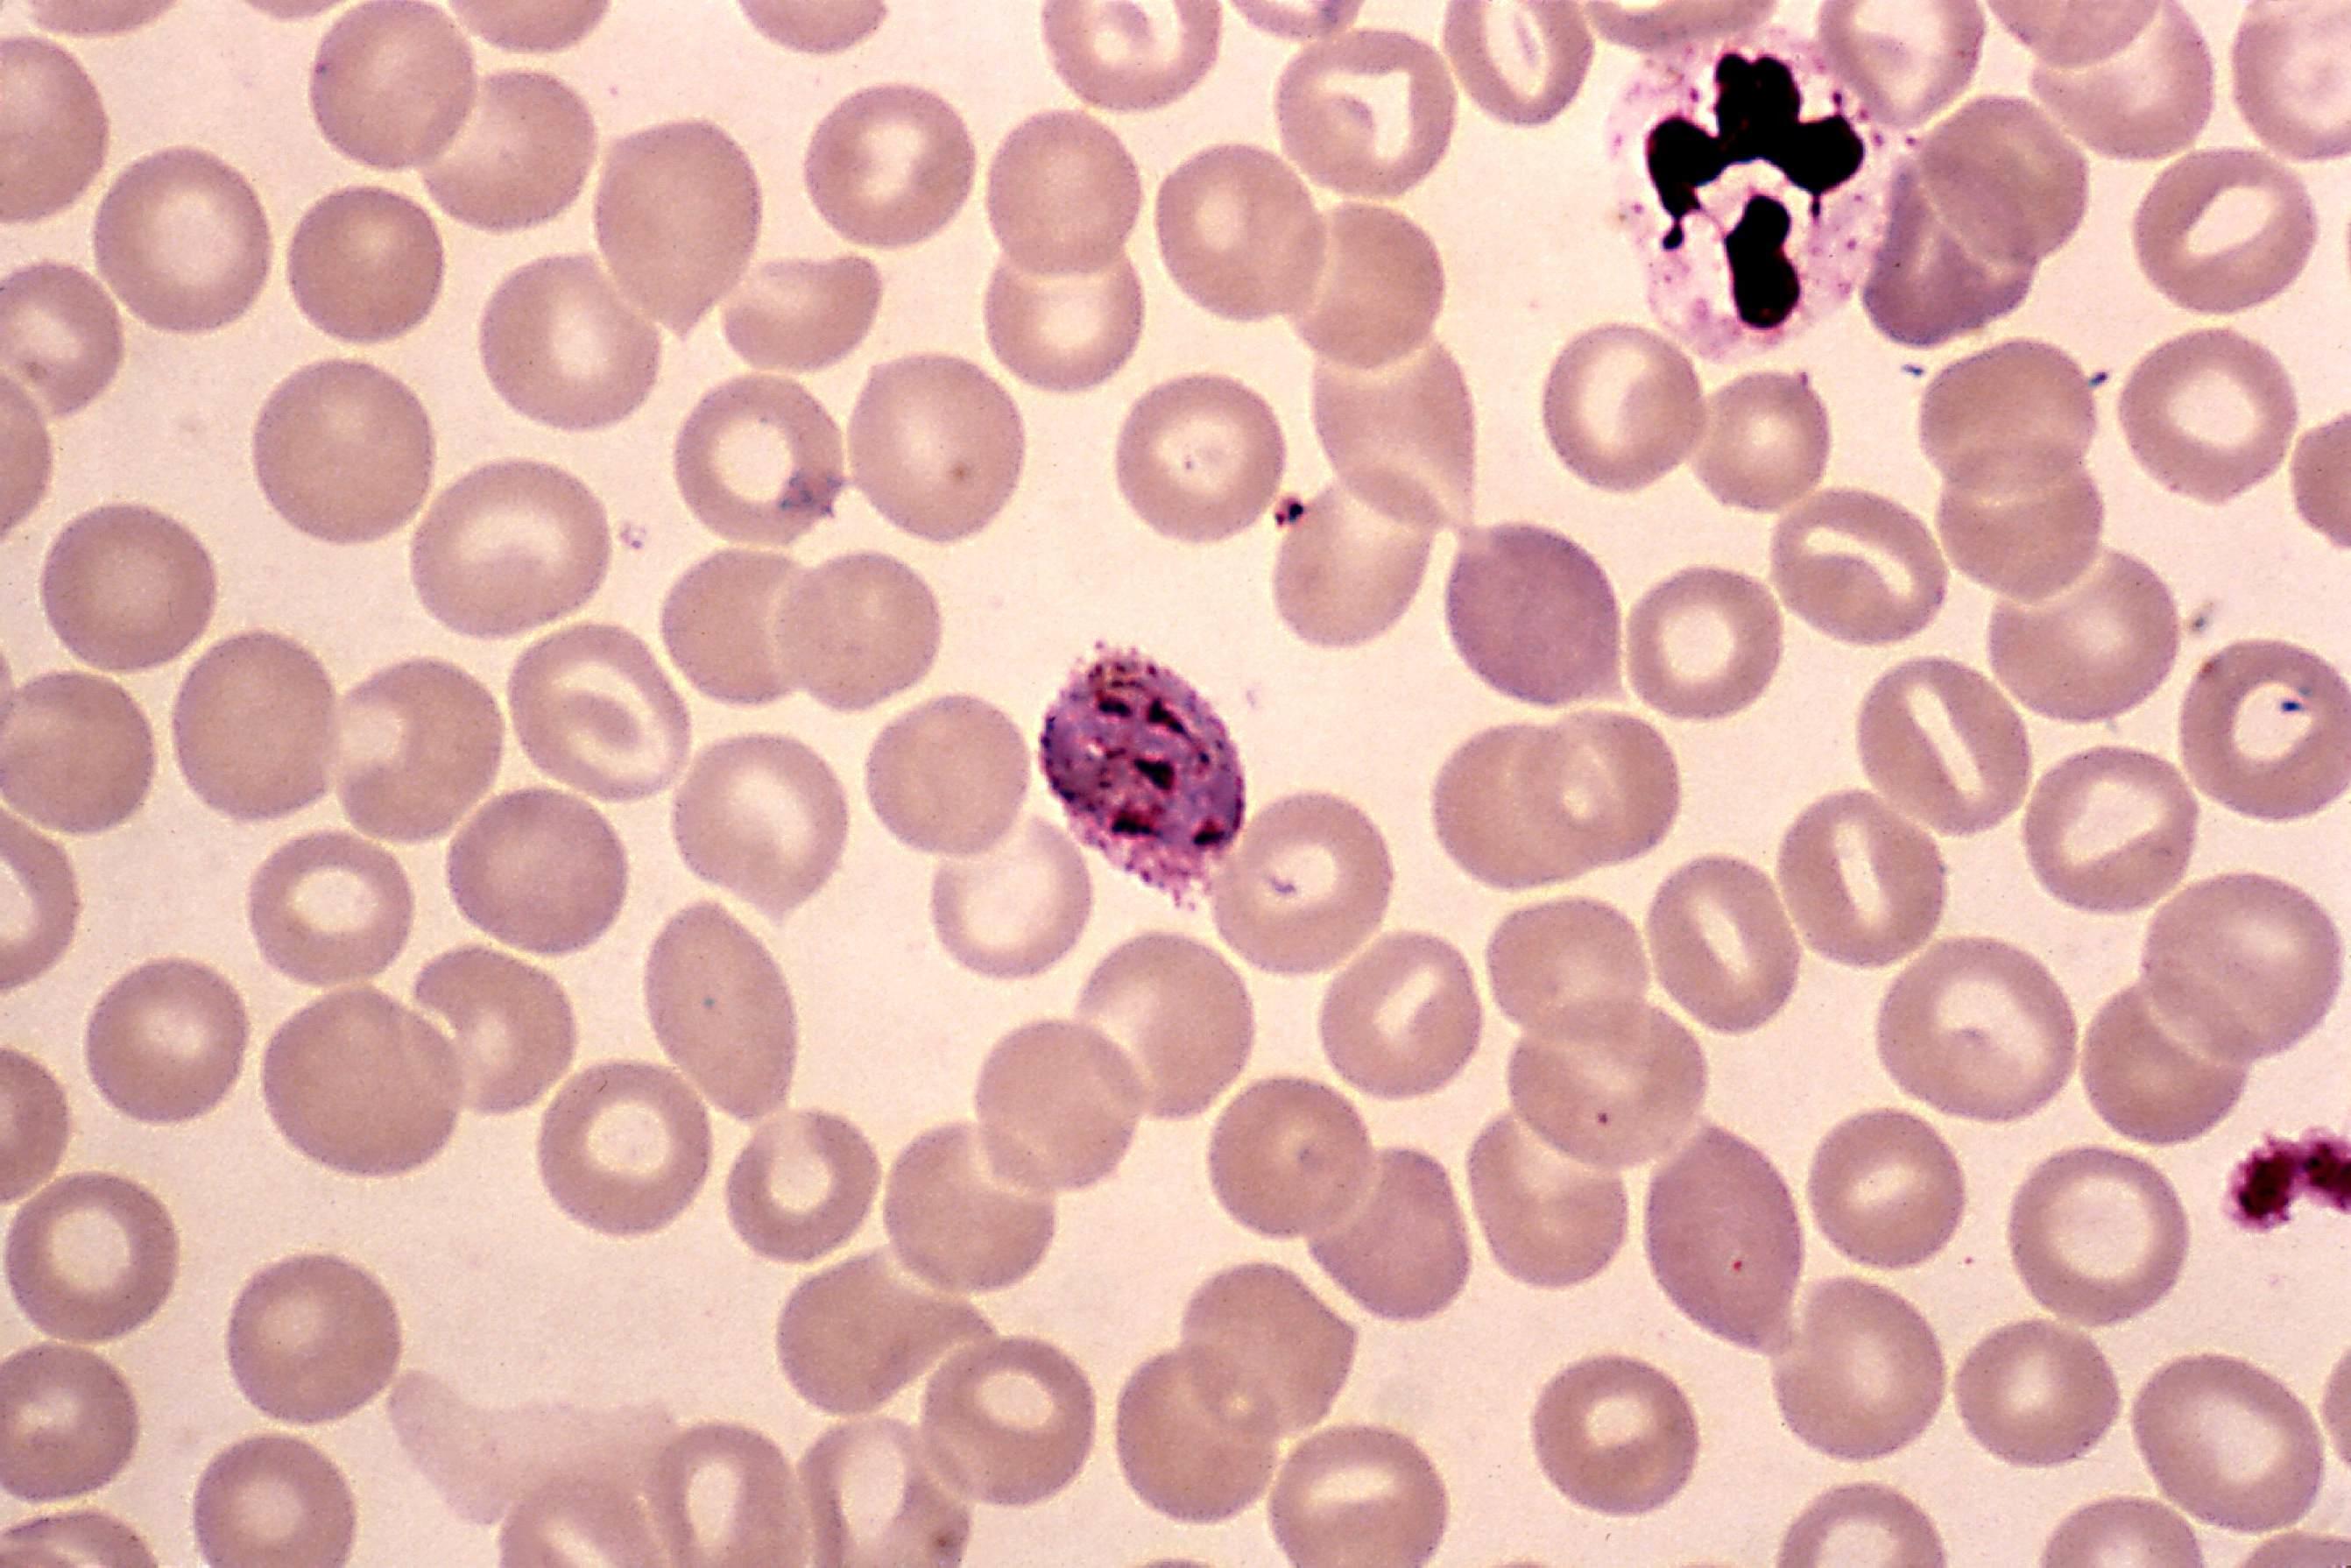
Comment se nomment les cellules sanguines ?

« la biologie moléculaire trouve toute sa place dans le suivi des traitements, elle a permis de faire un grand bond en avant concernant le traitement et le suivi », Docteur Marie-Noëlle Mozziconacci, biologiste moléculaire, Institut Paoli-Calmettes, Marseille.
Située au sud de la Belgique, la Wallonie est la région la moins densément peuplée de Belgique. Elle a la chance de posséder une nature encore préservée et riche de nombreuses espèces d’animaux et de plantes. En effet, ces vastes étendues boisées comme la forêt d’Anlier constituent une richesse écologique incroyable.
En ce qui concerne les technologies, et le développement économique, la Wallonie est une région de Belgique très prospère. Elle possède l’un des réseaux autoroutiers et l’un des réseaux ferroviaires les plus denses de l’Union européenne. Elle peut également se targuer de posséder, malgré sa petite taille, de grands aéroports d’envergure internationale. Le premier se trouve à Liège et le second à Charleroi.
La recherche scientifique dans le domaine de la biologie et des biotechnologies est à la pointe en Région wallonne. Ce développement s’est surtout accéléré ces quelques dernières années en raison de la création de nombreux parcs scientifiques consacrés à la recherche et à l’innovation. On peut citer par exemple le science park de Louvain-la-Neuve, dans le nord de la Wallonie à proximité de la ville de Bruxelles. Le Sud n’est pas en reste puisque le Novalis Bussiness Center est un parc scientifique qui a été inauguré en 2013 à proximité de Marche-en-Famenne. Il se consacre essentiellement à la recherche dans le domaine de la biotechnologie, des anticorps monoclonaux et de la biologie moléculaire.
Si vous êtes passionnés par la nature et la biologie, et que vous souhaitez vous inscrire dans une formation, il existe de nombreuses possibilités.
Retrouvez avec Superprof les principales possibilités pour suivre des cours de biologie en Wallonie, notamment en explorant les divers cours biologie 3eme proposés.
Étudier les sciences biologiques à Bruxelles

Capitale de la Belgique et capitale de l’Union européenne, la ville de Bruxelles héberge la majorité des institutions européennes, comme le Parlement européen. Celui-ci se trouve dans le quartier européen situé à proximité de la rue de la loi et du rond-point Schuman.
La ville de Bruxelles est mondialement connue pour abriter un monument qui fut érigé pour l’exposition universelle de 1958, l’Atomium. De nombreuses personnes pensent qu’il symbolise les provinces belges. Il n’en est rien, puisque l’Atomium représente la maille d’un cristal de fer agrandi plus de 165 milliards de fois.
Dans le cœur même de la capitale belge, se trouve l’une des plus belles places du monde, la Grand -Place de Bruxelles. Elle se trouve non loin de la rue des bouchers et de la rue au marché aux herbes et abrite de magnifiques bâtiments comme l’hôtel de ville, la maison du roi les différentes maisons des corporations.
Si vous vous intéressez aux sciences biologiques et que vous êtes à la recherche d’une formation, Superprof vous propose les meilleurs endroits pour suivre des cours de biologie à Bruxelles :
- l’université catholique de Louvain situé à Louvain-la-Neuve à quelques kilomètres du centre-ville de Bruxelles propose un bachelier en sciences biologiques, ainsi qu’un master et un doctorat. Lors du bachelier, après une première année de remise à niveau de tous les étudiants, la deuxième et la troisième année voient arriver des cours de biologie, de biochimie, de physiologie ou encore d’anatomie. En plus des cours magistraux, de nombreuses séances d’exercices permettent aux étudiants d’assimiler la théorie vue en cours notamment en ce qui concerne les mathématiques, la chimie et la physique. La formation de l’étudiant se trouve encore complété par de nombreuses heures de travaux pratiques en laboratoire afin de le conforter dans le choix de son futur métier ;
- la haute école Léonard de Vinci de Bruxelles se trouve au sein même de l’institut Paul Lambin sur le campus de l’UCL à Woluwe-Saint-Lambert. Elle organise une formation de technologue de laboratoire sous la forme d’un bachelier en biologie médicale. Les cours de biologie de première année sont dispensés avec les étudiants du bachelier en chimie. À partir de la deuxième année, les cours sont essentiellement centrés sur la biologie médicale et les sciences médicales. Au terme de la dernière année, les étudiants doivent réaliser dix semaines de stage dans un laboratoire universitaire et 3 × 5 semaines de stage dans un laboratoire de biologie clinique.
Apprendre la biologie dans la cité ardente

La ville de Liège, connue sous le nom de cité ardente, est certainement l’une des villes de Wallonie les plus internationales. En effet, elle se situe à proximité de la ville de Maastricht aux Pays-Bas et de la ville d’Aix-la-Chapelle en Allemagne.
Durant de nombreux siècles, la cité de Tchantchès faisait partie de l’Empire romain germanique et était même l’une de ses principales villes. Bien plus tard, elle tomba sous le joug des Princes évêques qui formèrent la principauté de Liège. Leur palais situé sur la place Saint-Lambert est utilisé de nos jours comme palais de justice.
La ville de Liège est aujourd’hui l’une des villes les plus étudiantes de Wallonie. De nombreux étudiants venant de toutes les régions du pays fréquentent les différentes facultés de son université ou encore les nombreuses hautes écoles de la ville.
Si vous souhaitez étudier les sciences, il existe Liège de nombreuses possibilités aussi bien par l’enseignement supérieur de type long ou l’enseignement supérieur de type court. Pour devenir biologiste, Superprof propose les différentes possibilités pour suivre des formations en biologie à Liège :
- l’université de Liège propose une formation complète pour devenir biologiste. Les cours ont lieu sur le campus du Sart Tilman au sein de la faculté des sciences. Les sciences biologiques enseignées au niveau du bachelier, du master et du doctorat permettent à l’étudiant de découvrir les êtres vivants sous tous leurs aspects. Parmi les cours dispensés, on distingue la biochimie, la biologie moléculaire et cellulaire, la bio-informatique et la biologie des organismes. Lors du master, les étudiants peuvent choisir une spécialisation en agro-écologie, en océanographie ou en sciences et gestion de l’environnement ;
- la haute école de la province de Liège située à proximité du pont de Fragnée à Liège organise un bachelier technologue de laboratoire. Il s’agit d’une formation contenant des cours de biologie qui permettent aux étudiants d’acquérir les connaissances indispensables pour pouvoir réaliser différentes analyses et différents examens de laboratoire sur des échantillons biologiques d’origine humaine, animale ou végétale. L’école propose deux options aux étudiants à savoir l’option chimie clinique et l’option cytologie.
Se former aux sciences biologiques à Namur
Située à la confluence de la Meuse et de la Sambre, la ville de Namur est célèbre pour abriter l’une des citadelles les mieux conservées d’Europe. Elle est située sur un promontoire rocheux le long de la Meuse, et ses fortifications ont été renforcées au 18e siècle par l’architecte français Vauban.
La cité mosane est également la capitale de la Wallonie. À ce titre, elle abrite sur un lieu-dit, le Grognon, le Parlement wallon qui siège dans un bâtiment qui autrefois était un hospice. Namur abrite de nombreux musées dont le magnifique musée de l’archéologie et elle se trouve être la ville de naissance d’un dessinateur et illustrateur wallon, Félicien Rops.
La ville de Namur est également une ville étudiante où se pressent chaque jour de nombreux étudiants qui fréquentent son université et ses nombreuses hautes écoles. Si vous êtes passionnés par le vivant et la nature, sachez qu’il existe de nombreuses solutions pour prendre des cours de sciences biologiques à Namur :
- l’université de Namur (UNamur) situé à proximité de la cathédrale Saint-Aubin en plein cœur de la cité wallonne, organise une formation complète en biologie, à savoir un bachelier, un master ainsi qu’un doctorat. Avant d’entamer cette formation, les élèves qui viennent de l’enseignement secondaire peuvent suivre des cours préparatoires en biologie générale, en physiologie, en histologie, en génétique et en biochimie. La formation en bachelier apporte à l’étudiant une solide formation scientifique aussi bien en biologie qu’en chimie, en mathématiques et en physique. Les étudiants acquièrent également une excellente formation pratique grâce à de nombreuses séances d’exercices et de travaux pratiques ;
- la haute école de la province de Namur située à Ciney à proximité de la capitale wallonne organise un bachelier en agronomie. Durant cette formation en trois ans, les étudiants découvrent la biologie adaptée à l’agronomie, mais également des cours de microbiologie, de chimie et de physique. À la fin de la première année, les étudiants en cours de biologie peuvent choisir entre la formation en agro-industrie ou la formation en environnement.
Découvrir les sciences de la vie et la biologie dans la cité de Spirou

La cité carolégienne fut durant les siècles passés surnommés le « pays noir » en raison de l’activité sidérurgique et minière qui y régnait à l’époque. En effet, durant tout le 19e siècle et une bonne partie du 20e, Charleroi vivait exclusivement de la métallurgie et de la production de ses hauts-fourneaux, mais aussi de l’extraction du charbon. Cette époque est maintenant révolue et il ne reste plus que quelques terrils et des friches industrielles. Certaines d’entre elles ont retrouvé une nouvelle vie en étant transformées en lieu d’exposition.
Depuis plusieurs années la ville de Charleroi est devenue la capitale sociale de la Wallonie, mais elle est également la capitale mondiale de la bande dessinée. Elle doit cela à la présence de l’une des plus importantes maisons d’édition de bandes dessinées belges, les éditions Dupuis à Marcinelle. Si vous êtes passionnés par le domaine scientifique et que vous souhaitez suivre des cours, Charleroi ne possède pas sa propre université, mais de grandes universités belges, comme l’UCL ou l’ULB, disposent de facultés dans la ville du Marsupilami.
Il existe par exemple de nombreuses possibilités pour découvrir la biologie à Charleroi :
- l’université de Mons, UMons, possède à Charleroi une faculté pour l’enseignement des sciences biologiques. La première année du bachelier en sciences biologiques est une année à la fin de laquelle les étudiants peuvent choisir entre une option en biologie, en chimie, en sciences biomédicales ou en pharmacie. Cette formation polyvalente permet aux étudiants d’acquérir d’excellentes connaissances en mathématiques, en physique en chimie, et en biologie. Dans les cours de biologie, ils apprennent la biologie classique, l’anatomie, ou encore la zoologie ;
- la haute école Condorcet située à Montignies-sur-Sambre près de Charleroi organise une formation de bachelier technologue de laboratoire médical spécialisé en biologie médicale. Il s’agit d’une formation qui conduit à un titre de laborantin protégé par des arrêtés royaux relatifs à la profession de technologue de laboratoire médical. Parmi les cours de biologie enseignés, les étudiants découvrent la biochimie organique, l’hématologie, la microbiologie, la cytologie ou encore la physiopathologie.
Suivre une formation en biologie dans la cité montoise
Chaque année à la Sainte Trinité, la ville de Mons organise l’une des festivités folkloriques les plus attendues par la population. La ducasse de Mons ou Doudou raconte la victoire de Saint-Georges contre le dragon. Depuis plusieurs années maintenant la ducasse de Mons fait partie du patrimoine oral et immatériel de l’humanité de l’UNESCO.
La cité montoise est également un joyau de l’architecture puisque parmi les magnifiques bâtiments de la ville on retrouve la Grand-Place et son magnifique hôtel de ville, le beffroi ainsi que la magnifique cathédrale Sainte Waudru construite en style gothique brabançon.
L’université de Mons, considérée comme l’une des plus petites universités de Belgique, n’en est pas moins une grande université en ce qui concerne la richesse des matières enseignées. Les amateurs de science seront comblés puisque l’université montoise organise de nombreuses formations. Il existe également quelques hautes écoles qui permettent à tout un chacun d’obtenir un diplôme d’études supérieures.
Si vous souhaitez devenir biologistes, il existe plusieurs possibilités pour suivre des cours de biologie à Mons :
- située à proximité du musée des beaux-arts, l’université de Mons propose un cursus complet en sciences biologiques soit un bachelier, un master et un doctorat. Le bachelier permet aux étudiants d’acquérir d’excellentes connaissances en biologie animale, en biochimie, en biologie cellulaire et moléculaire, en génétique, en physiologie et en microbiologie. Durant le master, les étudiants peuvent se spécialiser en biochimie, biologie moléculaire et cellulaire ou découvrir la biologie des organismes et l’écologie ;
- la haute école Condorcet située digue de Cuesmes à Mons propose un cursus pour devenir ingénieure industrielle en agronomie. La formation débute par un bachelier de trois ans pour découvrir l’agronomie et l’agro-industrie puis un master en deux ans. Les étudiants peuvent choisir l’orientation industrielle, fermentation ou environnement.
Résumer avec l'IA :










